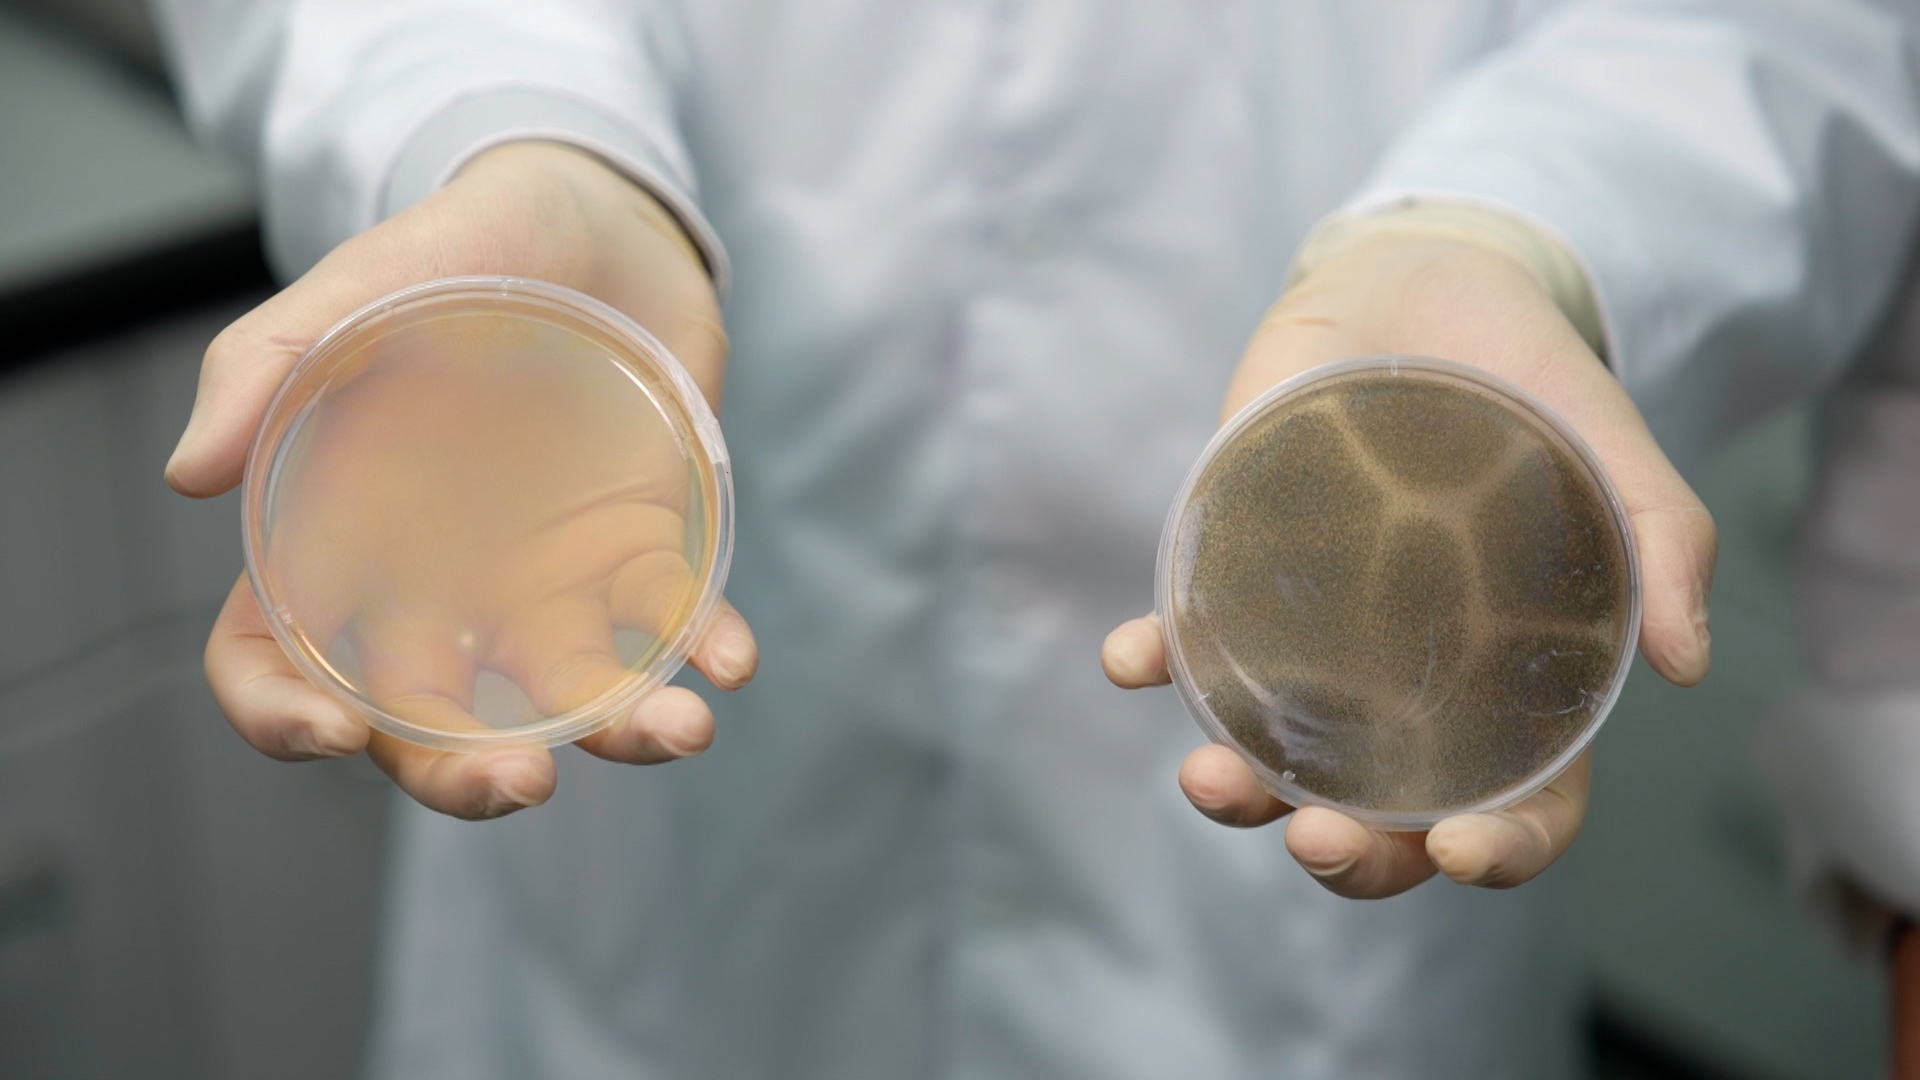
結果是，有噴防霉泡沫的浴簾培養皿，近乎是沒有霉菌再長出來，但沒有噴的，則還長出了很多霉菌。

嘩!為甚麼整間浴室都煙霧瀰漫?發生了甚麼事? 街坊們都表示,冬天時喜歡洗熱水澡,會比較舒服。不過,如果浴室沒有窗戶,或者關上窗,空氣不流通,這麼潮濕的環境,不只夏天,就連冬天,浴室也可能會出現很多「黑客」!是黑漆漆和一塊塊的霉菌呀!

化學系碩士級講師K. C. Daniel表示:「霉菌最喜歡的就是高溫高濕的環境,而冬天時香港人又喜歡關上窗洗熱水澡,令到浴室又暖又濕,室內外的溫差亦很大,這個就是霉菌最喜歡的環境。」
K. C. Daniel指:「要徹底清除霉菌,一定要由細胞的結構著手,一些黏附力強的防霉泡沫,能夠形成細密的泡沫層,深入霉菌的細胞,有效瓦解霉菌,連根拔起。」

K. C. Daniel進行實驗,他準備一塊培養了霉菌的瓷磚,將防霉泡沫噴上去,等一陣子,再觀察防霉泡沫可否將霉菌弄走。
實驗結果是,在瓷磚上噴了防霉泡沫後,瓷磚上的霉菌全都沒了。 K. C. Daniel表示:「清楚見到防霉泡沫可以滲透霉菌,並且去除。」


K. C. Daniel再進行一個實驗,他在家中的浴室剪了兩塊浴簾,碎片上有霉菌,他在其中一塊浴簾上噴上防霉泡沫,另外一塊浴簾則不作任何處理。
取樣之後,就將其放在適合霉菌生長的環境培育,再觀察噴了防霉泡沫和沒有噴防霉泡沫的分別。
結果是,有噴防霉泡沫的浴簾培養皿,近乎是沒有霉菌再長出來,但沒有噴的,則還長出了很多霉菌。
K. C. Daniel指:「由於防霉泡沫裏的漂潔成分,有助分解浴簾表面的霉菌,並且可以抑制霉菌生長。」
主持李旻芳進行測試,將防霉泡沫噴到充滿霉菌的地方, 就算牆壁時是直的,泡沫也可以依附。等了5分鐘後,霉菌一擦就能擦掉,而且一點也不刺鼻,還有些花香味。使用後,把噴嘴鎖上,那就行了。

即睇客戶資訊:Kao Magiclean

